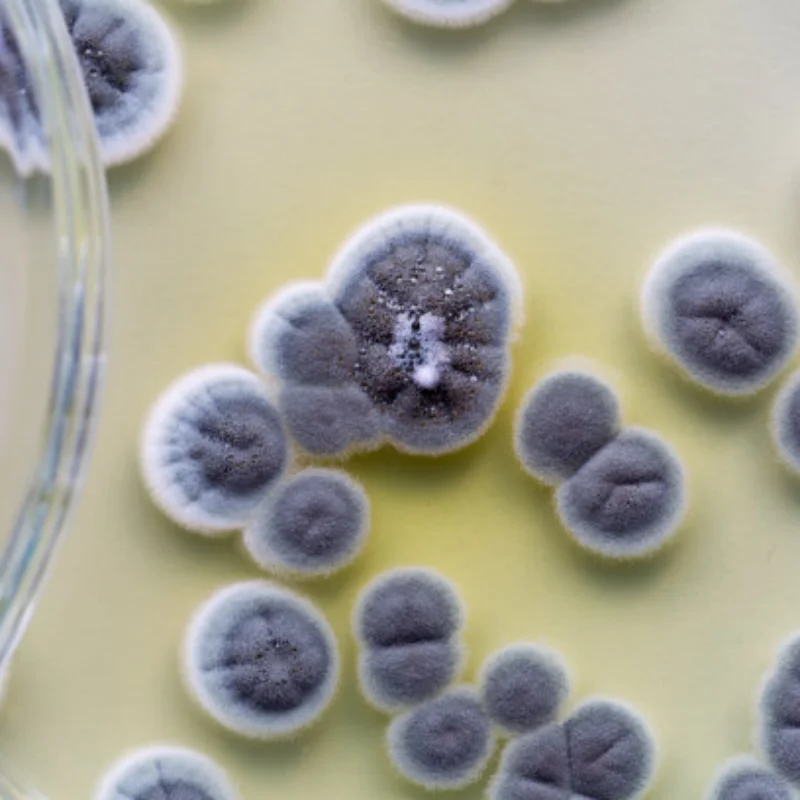
Металлическая ручка колеса для TRXS Mini Slash 4X4 108164-1, детали для обновления радиоуправляемого автомобиля, аксессуары

12 шт. новая атласная ткань, петля для волос, набор колец для волос, однотонная тканевая петля, веревка для волос
Price history chart & currency exchange rate
Customers also viewed

2,081.19 руб.
2025 spring and summer Europe, America, new solid color commuter wind lotus leaf collar loose long-sleeved top shirt women
aliexpress.com
440.91 руб.
Air Pump Decoration Resin Aeration Shell Fish Tank Aquarium 3D Simulation Hideout Artificial Shell Decor Underwater Oxygen
aliexpress.com
28,133.11 руб.
Customized. Valentine's Day Orange Acrylic Electronic Photo Frame Fantasy Photo Digital Player
aliexpress.com
1,702.36 руб.
Мужской винтажный свитер, кардиган без рукавов, трикотажный, на пуговицах, в стиле пэчворк, 6% шерсть, плотный, теплый, для осени и зимы, 7862
aliexpress.ru
1,032.24 руб.
Защитная пленка для BMAX MaxPad I11 Plus 10,4 дюйма, магнитная Обложка для планшетного ПК с ремешком на руку (T616)
aliexpress.ru
1,430.97 руб.
Тонкий декоративный контейнер для кистей для макияжа, держатель для косметических кистей, органайзер для хранения ручек, контейнер для руч...
aliexpress.ru
1,993.65 руб.
Акриловый календарь, прозрачный магнитный календарь для холодильника, магнитная доска, планировщик, ежемесячная доска для сухого стирания с линией, ежемесячный выходной
aliexpress.ru
4,285.75 руб.
Выпрямитель статора для Suzuki GSXR600 GSXR750 GSXR GSX R регулятор катушки 600 750-2006 2015 2016 2014 2013 2012 2011 2010
aliexpress.ru
180.66 руб.
DISCICI 2020 New Style Christmas Hairpin Set Bow Hairpin Christmas Tree Snowflake Clip Children's Lovely Hair Adornment WSH1059
aliexpress.com
599.00 руб.
Книжка-панорамка из серии Любимые сказки - У меня зазвонил телефон. Чуковский К.
toyway.ru
1,059.30 руб.
Женская юбка в рубчик, однотонная длинная юбка с прямым разрезом и пуговицами, весна-лето 2022
aliexpress.ru
1,932.37 руб.
Комплект постельного белья в европейском и американском стиле с изображением научной фантастики, милый детский комплект постельного белья...
aliexpress.ru
688.43 руб.
Кухонный шкаф вращающаяся стойка для полотенец тряпичный держатель для мытья тряпичный сливной Органайзер полка шпатель ложка для хранени...
aliexpress.ru
139.28 руб.
Octagon Stainless Steel Charms For Jewelry Making Supplies Geometric Hearts Charm Pendant Handmade Vintage Accessories Breloque
aliexpress.ru
270.59 руб.
Женская Повседневная трендовая Милая эстетичная Новая модная женская футболка с рисунком в виде перьев женская одежда с мультяшным принто...
aliexpress.ru
401.12 руб.
Сетчатые дышащие мужские кроссовки Air Shoo, спортивная обувь, весенняя обувь Shous, беговые кроссовки 47, мужская белая спортивная обувь для трекк...
aliexpress.ru
124.16 руб.
Шарики для сушки многоразового использования уменьшают морщины одежды и экономят время сушки бесплатно для стиральной машины шарики для с...
aliexpress.ru
620.78 руб.
Покерные карты четыре туза, ювелирные изделия, подарок, мужские запонки с родиевым покрытием
aliexpress.ru
2,874.67 руб.
Women'S Winter Parka Korean Corduroy Big Pocket Lamb Cashmere Lapel Thicken Casual Bread Coat Veste Grande Taille Pour Femme
aliexpress.com
6,331.12 руб.
Яйцеварка из нержавеющей стали, автоматическое выключение, бытовая многофункциональная Пароварка для завтрака и яиц, 220 В, 50 Гц, маленькая м...
aliexpress.com
157.65 руб.
новые прибытия 100 шт. звезда крафт-бумага этикетка свадьба рождество halloween party пользу цена подарочная карта багажные бирки белый черн
dhgate.com
259.45 руб.
Birthday Reminder Wall Calendar Wooden Plaque with Interchangeable Discs Best Gift for Wedding Anniversary Valentine Mothers Day
aliexpress.ru
347.79 руб.
8Pcs Stainless Steel Rhinestone Nose Studs Painless Safe Nose Rings Elegant Piercing Jewelry for Men Women Piercing Jewelry
aliexpress.ru
779.95 руб.
Pokemon Blokees DIY Строительный блок Пикачу Иви Сприigatito Charmander Psyduck Charmander Фигурка Аниме Модель Детская игрушка в подарок
aliexpress.ru
530.05 руб.
Металлическая ручка колеса для TRXS Mini Slash 4X4 108164-1, детали для обновления радиоуправляемого автомобиля, аксессуары
aliexpress.ru
2,049.36 руб.
Double Bearing Mountain Bicycle Axial System Quick Release 32 Holes 8 9 10 11 Speed Double Peilin Dt200
aliexpress.com


















